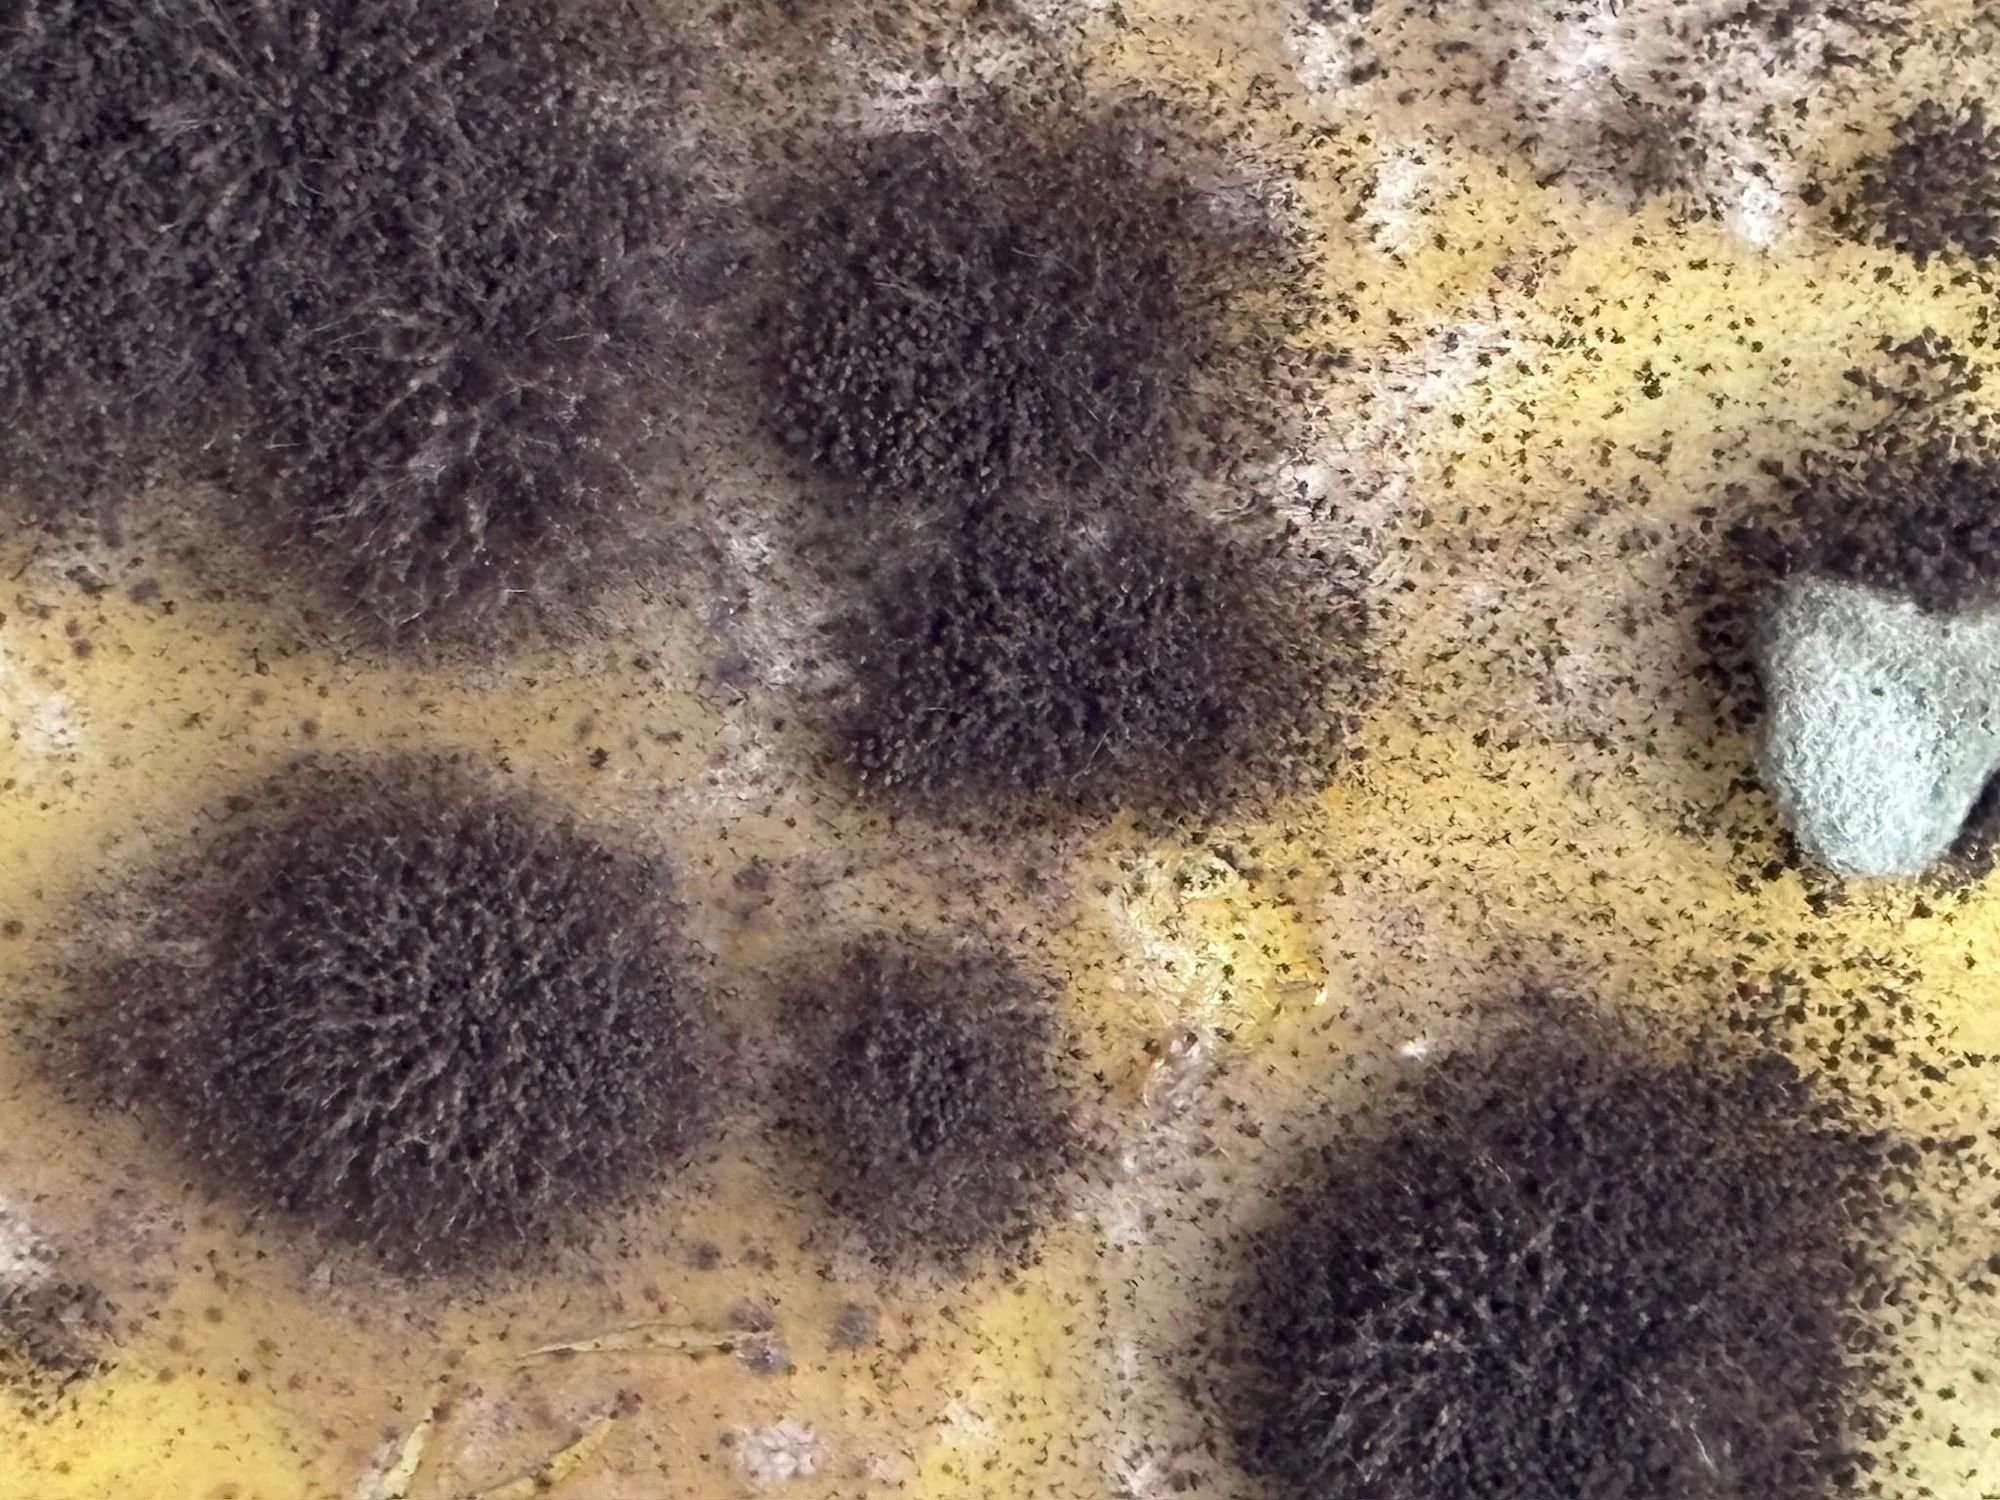
Nel cuore del danno nasce una ricerca tra arte e scienza

Nel cuore del danno nasce la resilienza. Attraverso lo studio delle muffe e la tecnica della gum print, trasformo il degrado in linguaggio visivo: una ricerca tra arte e scienza dove la materia rivela una nuova vitalità e una narrazione inaspettata.
Read MoreNel cuore del danno nasce una ricerca tra arte e scienza